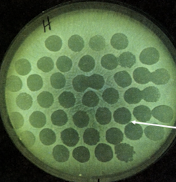

What is a tranformant?
• Transformant- cell that has taken DNA by bacteria
What is a competent?
• Competent- bacteria that can take up DNA naturally (i.e.
without artificial treatment)
What is Homologous recombination?
• Homologous recombination- identical or similar regions of
DNA align and exchange each other by excision-repair
– also known as allelic exchange or strand replacement (occurs a-lot in nature)
What is transfection?
• Transfection- uptake of viral DNA
What is the mechanism of transformation?
• DNA present from lysed cell, most will be degraded, but some may be taken up by another cell nearby. If this DNA offers that cell an advantage it will be replicated and incorporated as the cells reproduce.
Why is transformation important?
What is artificial transformation schemes?
introduce “foreign genes” into both eukaryotic and prokaryotic
cells. - allowed for the easy production of mutants to allow for
the definition of gene function e.g. virulence determinants.
What is seen in this image?

Bacteriophage

What are these dark circles representing in this image?
• Dark circles represent areas of Salmonella growth lysed by phage
What is the mechanism of transduction?
What would be the reason that bacteria would keep the new DNA?
It has to provide the cell an advantage.
What occurs in a lysogenic phase of transduction?
bacteria with new DNA gene becomes part of the cell and is inactivated. Can be reactivated later
• Chicken pox -> Shingles ( DNA remains part of that host cell for life and can be reactivated)
What occurs in the lytic phase of transduction?
Bacterial particles are replicated in cell and cell lyses releasing contents to infect more cells.
What casued the O antigen in salmonella?
• O antigens in salmonella have been brought in by bacteriophages.
What are the 3 extrachromosomal pieces of dna?
◦ Plasmids
◦ F- Factor ( via sex pillus)
◦ R- Factor
What is a plasmid?
Plasmids = genes of unknown origin and often not
necessary for growth; others contain genes encoding
virulence factors
What is an F Factor?
2) F-factor = fertility factor; genes promote replication
and transfer of the factor to recipient cells e.g. conjugation.
What is an R factor?
3) R-factor = F factor + genes encoding resistance to
specific antibiotics.
What is conjugation?
What are the 2 genes inside of an R factor?
◦ 1) Resistance transfer factor = RTF encodes origin of replication, sex pilius genes.
◦ 2) r-determinants = genes encoding antibiotic resistance, heavy metal resistance or other virulence factors (determinants), insertion sequences (IS)
What is transposons? How can they jump? What sites does this occur on? What will allow it to replicate?
Transposons- or insertion sequences/ jumping genes
• can jump between one region of chromosome to another, in and out of plasmid, ect.
• They do this due to sites called an IS regions ( insertion sequences)
• Transposons tend to go into certain regions more commonly in the gene.
• It only replicates if it can provide a benefit to that cell.
Are bacteria intelligent?
• Nope just replicate faster than us and they mutate faster, so we need to find ways to try to be 3 steps ahead. .
how can you prevent antibiotic resistance?
• Way to combat antibiotic resistance, is to not use the antibiotic.
What is a live attenuated vaccine?What are the pros and cons of live attenuated vaccines?
• Live: attenuated - limited growth in host
◦ Pros: allows for immune response
◦ Cons: can return to virulence if we are not careful, can cause mild symptoms of disease.